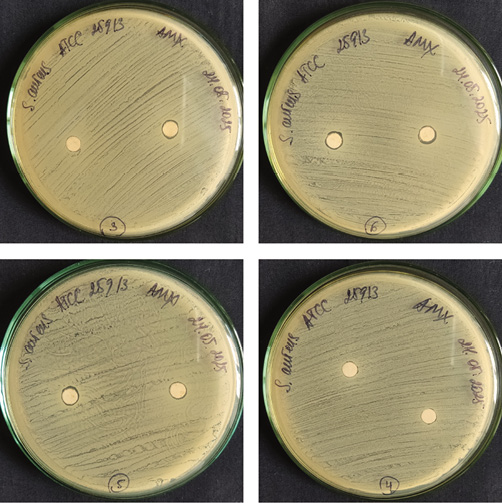

Перейти к:
Медовый гидрогель — перспективное антибактериальное покрытие нового поколения?
https://doi.org/10.47183/mes.2025-347
Аннотация
Введение. Разработка гидрогелевых покрытий — это перспективное направление для исследований в области терапии ожоговых повреждений. Гидрогели на основе меда обладают уникальными физико-химическими характеристиками: они прозрачны, хорошо впитывают экссудат и имеют низкие значения pH. Все это делает их идеальными кандидатами для применения не только в косметологии, но и в медицине для трансдермальной доставки различных лекарственных веществ.
Цель. Получение гидрогелей на основе полимеров и меда, сравнительный анализ их физико-химических характеристик и определение антибактериальной активности.
Материалы и методы. Использовали полученные гидрогели из хитозана и карбопола, содержащие в своем составе липовый мед в весовых концентрациях 25, 50 и 75%. Исследовали показатели: вязкость (на ротационном вискозиметре Brookfield); растекаемости (методом прессования); степень набухания образцов; стабильность (методом центрифугирования); высвобождение меда из образцов (в тесте высвобождения с помощью ERWEKA DT-820); анализ количественного содержания меда в буфере (методом спектрофотометрии). Исследование антибактериальных свойств in vitro проводили с использованием: Candida albicans ATCC 64550 — дрожжеподобный гриб; Staphylococcus aureus ATCC 25913 — грамположительная бактерия; Escherichia coli ATCC 25922 — грамотрицательная бактерия; Acinetobacter baumannii 897 — грамотрицательная бактерия; Enterobacter cloacae ATCC 13047 — грамотрицательная бактерия; Klebsiella pneumoniae ATCC 19606 — грамотрицательная бактерия. Статистическая обработка данных выполнена с помощью программного обеспечения DeltaX 3.0.
Результаты. Наилучший образец по показателю вязкости — гидрогель на основе 1% карбопола 940 с концентрацией меда 25%. Наименьшей растекаемостью обладали образцы на основе 1% карбопола ETD 2020 с концентрацией меда 50%. Наилучшая сорбционная емкость через 1 ч после начала испытания и через 3 ч продемонстрирована у образца на основе 3,5% низковязкого хитозана с концентрацией меда 25%. Наилучший результат высвобождения меда показал образец на основе 10% низковязкого хитозана с концентрацией меда 50%.
Выводы. Наиболее перспективными для дальнейшего изучения образцами по результатам исследования физико-химических и антибактериальных свойств признаны гидрогели на основе хитозана. В результате сравнительного анализа было выявлено, что образцы гидрогелей с концентрацией меда 75% не проходят испытание на стабильность, что делает невозможным их применение в качестве терапевтической системы доставки. На основании исследования физико-химических показателей исследованных гидрогелей, а также их антибактериальных свойств можно рекомендовать провести испытания смешанного гидрогеля на основе карбопола 940 и 3,5% низковязкого хитозана.
Для цитирования:
Карпина Е.Н., Федотова Е.В., Зарипова Ф.Ф., Криворотов Д.В., Радилов А.С. Медовый гидрогель — перспективное антибактериальное покрытие нового поколения? Экстремальная биомедицина. 2026;28(1):146-156. https://doi.org/10.47183/mes.2025-347
For citation:
Karpina E.N., Fedotova E.V., Zaripova F.F., Krivorotov D.V., Radilov A.S. Honey-based hydrogel: A promising new-generation antimicrobial coating? Extreme Medicine. 2026;28(1):146-156. https://doi.org/10.47183/mes.2025-347
ВВЕДЕНИЕ
Ожоги — одна из наиболее распространенных травм как в быту, так и на производстве. В комбустиологии ожоги подразделяют на химические, термические, радиационные, комбинированные. Склонность к поражениям различными бактериями и необходимость к стимуляции регенерации кожи — объединяющий фактор всех этих групп. Гидрогели обладают рядом свойств, которые обусловливают преимущества их использования в комбустиологии: способность к абсорбции, биодеградируемость, сходство с внеклеточным матриксом, которое обеспечивает биосовместимость, отсутствие адгезии, возможность доставки противомикробных компонентов непосредственно в очаг поражения [1–3]. Данные свойства определяют возможную эффективность применения гидрогелей при лечении ожогов. Отдельной популярностью в настоящее время сейчас пользуются гидрогели на основе смарт-полимеров, способных реагировать на внешние стимулы: уровень рН, температуру, концентрацию активных форм кислорода (АФК) [3]. Одним из перспективных направлений является разработка синтетических гидрогелей с запрограммированным высвобождением биологически активных веществ, способных влиять на патогенез раневого процесса [4].
Способность к поглощению жидкостей поддерживает определенную влажность за счет набухания гидрогеля. Это позволит контролировать уровень экссудата, а также обеспечить необходимую солюбилизацию. Биосовместимость полимеров, входящих в состав гидрогеля, позволяет нивелировать риск возникновения иммунного ответа и отторжения организмом. Полимерные гидрогелевые покрытия хорошо связываются с различными биоактивными и лекарственными веществами, что позволяет доставлять антимикробные, противовоспалительные, обезболивающие и другие лекарственные вещества в организм [5]. Некоторые гидрогели могут и сами проявлять антибактериальные свойства, например синтетический полимерный гидрогель на основе поли(2-гидроксиэтилметакрилата) [4]. O. Maikovych и соавт. также продемонстрировали антибактериальный эффект на S. aureus и E. coli гидрогелей на основе желатина, сшитого полиэтиленгликолем [6].
Как правило, гидрогели для комбустиологии получают на основе природных полимеров, таких как хитозан, альгинат натрия, коллаген, гиалуроновая кислота, целлюлоза, желатин и т.д. В этой области могут быть перспективными синтетические полимеры, такие как поливиниловый спирт, полиакриламид, полиэтиленгликоль, карбопол и др. В настоящее время наиболее популярны гибридные гидрогели. Их получают путем сочетания двух или более синтетических и природных полимеров. За счет физико-химических особенностей полимеров, входящих в состав таких гибридных гидрогелей, можно варьировать область их применения [7]. Одним из примеров таких сочетаний является гидрогель на основе карбоксиметилцеллюлозы и хитозана, полученный реакцией Шиффа. Гидрогель обладал превосходной адгезией к тканям и был рекомендован для заживления глубоких ожогов [8].
Антибактериальные свойства меда вызывают интерес исследователей очень давно. Была неоднократно научно доказана его эффективность в отношении патогенных и непатогенных микроорганизмов, среди которых бактерии, дрожжи, а также грибы. Известно, что его противомикробная активность связана с низкими значениями pH (кислая среда), содержанием пероксида водорода, сахаров и белка [9]. Высокое содержание сахаров обеспечивает создание защитного барьера, который препятствует развитию микроорганизмов. Уменьшение количества несвязанных молекул воды в меде ведет к снижению роста и развития микроорганизмов [10].
Противогрибковые свойства меда также связаны с его физико-химическими свойствами. Считается, что фенольные соединения, содержащиеся в меде, способствуют денатурации белковых молекул, что значительно снижает стабильность клеточных мембран и впоследствии приводит к их разрушению у грибов [11][12].
Не менее интересны для комбустиологии и противовоспалительные свойства меда. Воспаление — это процесс, обусловленный реакцией иммунной системы организма на различные повреждения или на проникновение чужеродных патогенных микроорганизмов. Считается, что эффективность меда в купировании воспалительного процесса связана с фенольными соединениями, входящими в его состав. Галангин (один из флавоноидов меда) ингибирует активность циклооксигеназы (ЦОГ) и липооксигеназы-2, снижая экспрессию циклооксигеназы-2 (ЦОГ-2), и ограничивает действие полигалактуроназы [13]. Некоторые авторы описывают действие меда на молекулярные механизмы иммунного ответа за счет индукции выработки NF-κB (транскрипционный фактор), TNF-α (фактор некроза опухоли альфа), провоспалительных цитокинов IL-6 (интерлейкин-6), IL-1β (интерлейкин-1β) [14].
Помимо противомикробных свойств, в исследованиях отмечается также ранозаживляющая способность меда. Активность может быть как бактериостатической, так и бактерицидной, в зависимости от разновидности меда. При контакте меда с раной происходит снижение активности протеаз в области повреждения, увеличивается выделение кислорода из гемоглобина и стимулируются фибробласты и макрофаги, а выработка перекиси водорода стимулирует фактор роста эндотелия сосудов и стерилизует рану. Таким образом, мед можно использовать как компонент, входящий в состав перевязочного материала [15].
Для предотвращения развития патогенных микроорганизмов при заживлении ожогов необходимо поддерживать оптимальный уровень выделяемого экссудата. Мед обладает существенным осмотическим потенциалом, что способствует выделению лимфатической жидкости, которая, в свою очередь, промывает и обеззараживает рану, а также способствует удалению инородных частиц из раневого ложа. Благодаря осмотическому потенциалу использование меда в качестве раневой повязки значительно снижает риск набухания и сморщивания кожи, так как мед впитывает влагу и защищает рану от гипергидратации [16][17].
Цель данного исследования — получение гидрогелей на основе полимеров и меда, сравнительный анализ их физико-химических характеристик и определение антибактериальной активности.
МАТЕРИАЛЫ И МЕТОДЫ
В настоящей работе использовали мед липовый дальневосточный, приобретенный в магазине «Мед и Конфитюр» (сбор 2023 г., артикул: 00000001221 с сертификатом качества от поставщика), хитозан высоковязкий (3,5%, Sigma aldrich), хитозан низковязкий (3,5%, Sigma aldrich), карбопол 940 (1%, Lubrizol), карбопол ETD 2020 (1%, Acros Organics).
Приготовление гидрогелей из хитозана и карбопола
Гидрогели готовили по стандартной методике: навеску хитозана растворяли в слабоконцентрированном растворе уксусной кислоты при помощи гомогенизатора Heidolph Silent Crusher M (Германия) при скорости 9000 об/мин (рис. 1). Навеску карбопола растворяли в воде при помощи гомогенизатора при скорости 9000 об/мин. Полученные растворы полимеров при непрерывном перемешивании довели триэтаноламином (ТЭА) до нейтрального значения pH (pH = 6,0–7,0). Контроль pH осуществляли при помощи pH-метра (рН-150МИ, Россия). В качестве сшивающего агента и консерванта использовали полиэтиленгликоль (ПЭГ). Полученные растворы полимеров оставили на сутки в холодильнике для стабилизации и набухания.

Рисунок подготовлен авторами по собственным данным
Рис. 1. Методика приготовления образцов гидрогеля с медом
Приготовление гидрогелей с медом
Липовый мед растапливали в сушильном шкафу при температуре 45 °С и добавляли в гидрогели при постоянном перемешивании (рис. 1). Для каждого раствора полимера были выбраны следующие концентрации меда по массе: 25, 50 и 75%. Полученные гидрогели хранили в холодильнике в течение суток для стабилизации и лучшего распределения меда.
Вискозиметрические исследования
Исследование вязкости гидрогелей проводили при помощи ротационного вискозиметра Brookfield LV-SSR Brinell Viscometer (Китай). Эксперимент для каждого образца повторялся трижды. Было рассчитано среднее значение вязкости.
Исследование сорбционной способности
Готовили фосфатный буфер рН = 5,5, соответствующий оптимальному значению рН кожи человека, следующим образом: навеску 13,61 г калия дигидрофосфата растворяли в воде в мерной колбе на 1000 мл. Навеску 3,58 г динатрия гидрофосфата растворили в воде, доведя раствор до метки 100 мл. После чего смешали 964 мл раствора калия дигидрофосфата и 36 мл раствора динатрия гидрофосфата.
Сухие образцы заливали фосфатным буфером так, чтобы они были полностью погружены в жидкость. Образцы оставляли на час, затем сливали избыточную жидкость и взвешивали их. После этого образцы снова заливали буфером и производили взвешивание еще через два часа. Эксперимент для каждого образца повторялся трижды, было посчитано среднее значение для каждого образца.
Степень набухания определялась количеством жидкости, поглощенной 1 г сухого вещества, по формуле (1):
(1)
где Q — сорбционная емкость гидрогеля, г/г; m — масса набухшего образца, г; m0 — исходная масса образца, г; γ — влагосодержание образца геля, массовая доля.
Содержание влаги было измерено после высушивания образца до постоянной массы по формуле (2):
(2)
где m0 — исходная масса образца, г; mc — масса высушенного до постоянной массы образца, г.
Исследование растекаемости образца
Растекаемость гидрогелей оценивали методом прессования (рис. 2) [18]. Навеску 0,5 г каждого образца помещали между двумя предметными стеклами. На верхнее стекло помещали нагрузку массой 5 г, по истечении 5 мин линейкой измеряли диаметры образовавшихся капель. Измерения проводились в трех направлениях, при этом эксперимент для каждого образца повторялся трижды, и было посчитано среднее значение диаметра для каждого образца.

Рисунок подготовлен авторами по собственным данным
Рис. 2. Методика проведения исследования на растекаемость
Исследование стабильности гидрогелей
Исследование стабильности гидрогелей осуществляли методом центрифугирования (рис. 3). Каждый образец объемом 15 мл центрифугировали (центрифуга марки ZJMZYM Timing Medical Centrifuge, Китай) со скоростью 4000 об/мин на протяжении 10 мин. Затем проводили визуальную оценку образцов на наличие осадка или расслоения. Эксперимент для каждого образца повторяли трижды.

Рисунок подготовлен авторами по собственным данным
Рис. 3. Методика проведения исследования на стабильность. Тест на высвобождение меда из гидрогелей
В соответствии с Государственной фармакопеей1 в качестве модельной среды был выбран фосфатный буфер рН = 5,5. В ходе исследования был использован тестер растворимости марки ERWEKA DT-820 (Германия). Среду растворителя объемом 500 мл заливали в емкость, термостатируемую в водяной бане до температуры 32,0 ± 0,5 °С. Держатель с образцами погружали в емкость со средой растворения, после чего запускали установку с вращательным механизмом на протяжении четырех часов.
По прошествии каждого часа осуществляли отбор проб. Пробы отбирали из средней по высоте части среды растворения на расстоянии не ближе 10 мм от внутренней стенки сосуда. Эксперимент для каждого образца повторяли трижды и считали среднее значение высвободившегося вещества для каждого образца.
Спектрофотометрическое исследование высвободившегося меда
Анализ на количественное содержание меда в буфере проводили на спектрофотометре Carry 100 UV Vis (Agilent Technologies, США). Поглощение выделившегося меда измеряли при λmax 340 нм (пик флавоноидов).
На основании полученных значений коэффициентов поглощения по формуле (3) была рассчитана концентрация действующего вещества в каждой отобранной пробе:
(3)
где Ax, Aст — оптические плотности анализируемого и стандартного растворов соответственно; Cст — концентрация действующего вещества в стандартном растворе, г/мл.
Исследование антибактериальных свойств in vitro
Для исследования антибактериальных свойств полученных образцов были выбраны следующие микроорганизмы: Candida albicans ATCC 64550 — дрожжеподобный гриб; Staphylococcus aureus ATCC 25913 — грамположительная бактерия; Escherichia coli ATCC 25922 — грамотрицательная бактерия; Acinetobacter baumannii 897 — грамотрицательная бактерия; Enterobacter cloacae ATCC 13047 — грамотрицательная бактерия; Klebsiella pneumoniae ATCC 19606 — грамотрицательная бактерия. В качестве питательной среды для культивирования микроорганизмов диско-диффузионным методом использовали агар Мюллера – Хинтона (предоставлен ООО «Научно-исследовательский центр фармакотерапии» (НИЦФ)). Для предварительного контроля микробной загрязненности эмульсий применяли питательную среду № 1 ГРМ (ФБУН «Государственный научный центр прикладной микробиологии и биотехнологии» (ФБУН ГНЦ ПМБ)). Эксперименты по оценке антибактериальных свойств были выполнены в соответствии с рекомендациями Института клинических и лабораторных стандартов (CLSI)2 и Европейского комитета по тестированию чувствительности к противомикробным препаратам (EUCAST)3.
Производили инокуляцию агара штриховыми движениями в трех направлениях суспензией микроорганизмов, приготовленных в стерильном физиологическом растворе (плотность 5×10⁸ КОЕ/мл или 0,5 по стандарту McFarland) с целью получения сплошного газона. Спустя 15 мин после инокуляции диски, пропитанные образцами гидрогелей, помещали в чашки Петри, после чего их культивировали с микроорганизмами при температуре 35 °C в течение 20 ч. По окончании инкубации измеряли диаметры зон задержки роста с точностью до 1 мм. Для этого чашки Петри помещали на темную поверхность вверх дном и освещали лампой под углом 45° 4.
Статистическая обработка данных
Статистическая обработка данных проведена с помощью программного обеспечения DeltaX 3.0. Для обработки результатов использовали одновыборочный t-тест критерия Стъюдента. Данные представлены в виде среднего значения и стандартного среднеквадратичного отклонения (СКО).
РЕЗУЛЬТАТЫ И ОБСУЖДЕНИЕ
В целях сравнения физико-химических свойств гидрогелей были приготовлены образцы с различными весовыми концентрациями меда (25, 50, 75%). В ходе визуальной оценки было показано, что все образцы с концентрациями меда 25 и 50% одинаково прозрачны, однородны, обладают легким запахом меда, окрашены в желтый (для образцов с концентрацией 25%) или желтовато-коричневый цвет (для образцов с концентрацией 50%). Механических включений в данных образцах не обнаружено. Образцы из хитозана и из карбопола с концентрацией меда 50% представляли собой вязкую жидкость, в отличие от образцов из карбопола с концентрацией меда 25%. Образцы из карбопола с концентрацией меда 25% имели гелеобразную структуру.
Анализ потенциометрических исследований (табл. 1) показал, что добавление меда в состав гидрогелей способствовало снижению значения показателя рН. Известно, что в зависимости от типа кожи показатель рН может варьировать от 4 до 7. Поскольку полученные нами результаты находятся в разрешенном диапазоне, гидрогели с медом можно считать применимыми для трансдермального способа введения.
Таблица 1. Результаты потенциометрического исследования*
Названиеполимера | Концентрация меда, % | Показатели рН растворов полимеров после доведения триэтаноламином | Показатели рН гидрогелей после добавления меда |
3,5% Хитозан высокой вязкости | 25 | 6,5 | 6,4 |
50 | 6,2 | ||
75 | 6,3 | ||
3,5% Хитозан низкой вязкости | 25 | 6,3 | 6,2 |
50 | 6,3 | ||
75 | 5,3 | ||
1% Карбопол 940 | 25 | 6,3 | 6 |
50 | 5,8 | ||
75 | 5,7 | ||
1% Карбопол ETD 2020 | 25 | 6,3 | 5,9 |
50 | 5,8 | ||
75 | 5,7 |
Таблица составлена авторами по собственным данным
Примечание: * в таблице представлены усредненные значения.
Показатели вязкости образцов также зависели от введения меда в состав гидрогелей (табл. 2). Было показано, что вязкость снижалась при увеличении концентрации меда в составе гидрогелей. Такая закономерность была характерна для всех образцов, за исключением гидрогелей на основе высоковязкого хитозана. Наилучшими показателями для трансдермального введения обладали образцы на основе карбопола 940 с концентрацией меда 25%.
Таблица 2. Результаты исследования вязкости гидрогелей*
Название полимера | Концентрация меда, % | Показатели вязкости растворов полимеров, сП | Показатели вязкости гидроглей после добавления меда, сП |
3,5% Хитозан высокой вязкости | 25 | 9,2 | 7,2 |
50 | 4,9 | ||
75 | 6,8 | ||
3,5% Хитозан низкой вязкости | 25 | 13,28 | 4,24 |
50 | 4,3 | ||
75 | 1,98 | ||
1% Карбопол 940 | 25 | 25,68 | 10,96 |
50 | 5,6 | ||
75 | 1,2 | ||
1% Карбопол ETD 2020 | 25 | 18,08 | 8 |
50 | 5,12 | ||
75 | 1,1 |
Таблица составлена авторами по собственным данным
Примечание: * в таблице представлены усредненные значения; сП — сантипуаз.
Для определения сорбционной емкости было вычислено влагосодержание каждого образца в массовых долях по формуле (2). Результаты расчетов влагосодержания представлены в таблице 3.
Таблица 3. Оценка набухающей способности гидрогеля*
Название полимера | Концентрация меда, % | Содержание влаги, % | Среднеквадратичное отклонение (СКО) |
3,5% Хитозан высокой вязкости | 25 | 0,63 | 0,03 |
50 | 0,65 | 0,02 | |
3,5% Хитозан низкой вязкости | 25 | 0,63 | 0,04 |
50 | 0,68 | 0,03 | |
1% Карбопол 940 | 25 | 0,67 | 0,06 |
50 | 0,67 | 0,07 | |
1% Карбопол ETD 2020 | 25 | 0,61 | 0,05 |
50 | 0,60 | 0,06 |
Таблица составлена авторами по собственным данным
Примечание: * в таблице представлены усредненные значения.
Результаты исследования сорбционной емкости гидрогелей представлены в таблице 4. Наибольшей сорбционной емкостью обладали образцы с наименьшей концентрацией меда независимо от типа полимера, на основе которого они были приготовлены. Наблюдения проводили в течение 1 и 3 ч. Данные промежутки времени выбраны исходя из предполагаемого времени экспозиции будущего покрытия.
Таблица 4. Результаты исследования сорбционной емкости образцов*
Название полимера | Концентрация меда, % | Сорбционная емкость через 1 ч | СКО | Сорбционная емкость через 3 ч | СКО |
3,5% Хитозан высоковязкий | 25 | 10,44 | 0,09 | 7,24 | 0,05 |
50 | 2,74 | 0,08 | 0,53 | 0,07 | |
3,5% Хитозан низковязкий | 25 | 14,63 | 0,13 | 14,37 | 0,11 |
50 | 5,34 | 0,08 | 1,23 | 0,02 | |
1% Карбопол 940 | 25 | 7,33 | 0,06 | 10,00 | 0,04 |
50 | 3,16 | 0,11 | 3,50 | 0,06 | |
1% Карбопол ETD 2020 | 25 | 4,71 | 0,07 | 6,50 | 0,09 |
50 | 2,57 | 0,03 | 4,54 | 0,03 |
Таблица составлена авторами по собственным данным
Примечание: * в таблице представлены усредненные значения.
Также следует отметить, что сорбционная емкость гидрогелей на основе хитозана через 3 ч снизилась, что связано с тем, что высвобождение вещества в среду буферного раствора у образцов на основе хитозана происходит достаточно быстро. Данная тенденция была наглядно продемонстрирована в тесте высвобождения. У образцов на основе карбопола наблюдалась противоположная тенденция.
Наилучшие сорбционные показатели продемонстрировали образцы на основе низковязкого хитозана с концентрацией меда 25% через 1 и 3 ч. У данного образца были получены наибольшие значения сорбционной емкости — 14,63 г/г. Кроме того, через 3 ч значительного снижения сорбционной емкости не наблюдали. Самые низкие показатели наблюдали у образца на основе высоковязкого хитозана с концентрацией меда 50%. Образец обладал небольшой сорбционной емкостью через 1 ч эксперимента — 2,74 г/г, а через 3 ч сорбционная емкость понизилась более чем в 5 раз и составила 0,53 г/г.
Результаты исследования растекаемости образцов с учетом среднеквадратичного отклонения (СКО) представлены в таблице 5. Установлено, что при повышении концентрации меда диаметр капель образцов становился меньше, что говорит о снижении растекаемости гидрогеля. При сравнении образцов выявлено, что наилучшей растекаемостью обладают образцы низковязкого хитозана. Наименьшим значением растекаемости, 0,55 см, обладали образцы на основе карбопола ETD 2020 с концентрацией меда 50%, а также образцы на основе высоковязкого хитозана с концентрацией меда 50%, что делает их более предпочтительными для использования в качестве трансдермального покрытия. Эти данные коррелируют с результатами, полученными ранее другими авторами [19]. В будущем имеет смысл исследовать растекаемость гидрогеля смешанного типа: карбопол ETD 2020 и хитозан низкой вязкости. Предположительно такой гидрогель будет лучше распределяться по ране, не затекая при этом за ее пределы.
Таблица 5. Результаты исследования растекаемости
Название полимера | Концентрация меда, % | Среднее значение, см | СКО |
3,5% Хитозан высоковязкий | 25 | 1,03 | 0,09 |
50 | 0,76 | 0,07 | |
3,5% Хитозан низковязкий | 25 | 1,66 | 0,13 |
50 | 1,36 | 0,06 | |
1% Карбопол 940 | 25 | 1,00 | 0,09 |
50 | 0,93 | 0,12 | |
1% Карбопол ETD 2020 | 25 | 1,01 | 0,06 |
50 | 0,55 | 0,11 |
Таблица составлена авторами по собственным данным
В результате исследования стабильности гидрогелей было выявлено, что все образцы, за исключением образцов с концентрацией меда 75%, проходят испытание. После центрифугирования не было выявлено образования осадка или разделение фаз.
Для исследования высвобождения меда из гидрогелей были приготовлены образцы на основе 10% высоковязкого хитозана и 10% низковязкого хитозана вместо образцов 3,5%. Наилучшими показателями высвобождения меда обладал образец на основе низковязкого хитозана с концентрацией меда 50%. Данный образец показывает наибольшую скорость высвобождения меда уже после первого часа проведения эксперимента. В дальнейшем показатели высвобождения продолжали увеличиваться. Для остальных образцов характерно незначительное увеличение концентрации высвободившегося меда. Результаты исследования представлены на рисунке 4.

Рисунок подготовлен авторами по собственным данным
Рис. 4. Результаты высвобождения меда из гидрогелей
Различные сорта цветочного меда демонстрируют значения pH в диапазоне 3,5–4,1. Однако липовый мед является исключением. Как было продемонстрировано, его рН варьируется в пределах 4,5–7. Для комфортной жизнедеятельности большинства бактерий наиболее благоприятной является нейтральная или слабощелочная среда. Если pH среды меняется в сильнощелочную сторону (pH 8–14), происходит разрушение РНК и фосфолипидов клетки, и она погибает. В случае когда pH среды смещается в кислую сторону (1–6), происходит разрушение ДНК и АТФ. Для гнилостных бактерий наиболее губительной является кислая среда.
В ходе исследования in vitro было продемонстрировано, что образцы на основе низковязкого и высоковязкого хитозана, независимо от концентрации меда, проявляли антибактериальный эффект против бактерий Staphylococcus aureus (рис. 5).
Фотографии выполнены авторами
Рис. 5. Результаты исследования антибактериальных свойств гидрогелей на основе хитозана на бактериях Staphylococcus aureus
Кроме того, образцы на основе низковязкого и высоковязкого хитозана с концентрацией меда 25% проявляли антибактериальные свойства против бактерий Acinetobacter baumannii (рис. 6)

Фотографии выполнены авторами
Рис. 6. Результаты исследования антибактериальных свойств гидрогелей на основе хитозана и меда концентрацией 25% на бактериях Acinetobacter baumannii
В ходе исследования также были обнаружены бактериостатические свойства — способность подавлять рост и развитие у образцов на основе низковязкого хитозана с концентрацией меда 25%, а также у образцов на основе карбопола ETD 2020 с концентрацией меда 25% (рис. 7) в отношении бактерий Klebsiella pneumoniae.

Фотографии выполнены авторами
Рис. 7. Результаты исследования антибактериальных свойств гидрогелей на основе хитозана низковязкого и меда концентрацией 25%, а также гидрогеля на основе карбопола ETD 2020 с концентрацией меда 25% на бактериях Klebsiella pneumoniae
Помимо этого, был обнаружен слабый бактериостатический эффект от гидрогелей на основе низковязкого и высоковязкого хитозана с концентрацией меда 25% на бактериях Escherichia coli (рис. 8), Enterobacter cloacae (рис. 9).

Фотографии выполнены авторами
Рис. 8. Результаты исследования антибактериальных свойств гидрогелей на основе хитозана и меда концентрацией 25% на бактериях Escherichia coli

Фотографии выполнены авторами
Рис. 9. Результаты исследования антибактериальных свойств гидрогелей на основе хитозана и меда концентрацией 25% на бактериях Enterobacter cloacae
Остальные образцы не проявили антибактериальных или бактериостатических свойств, что может быть связано со слабым высвобождением меда. Также не был обнаружен противогрибковый эффект от образцов, поскольку исследования на дрожжеподобном грибе Candida albicans не дали результатов. Это связано с тем, что оптимальный рН для жизнедеятельности Candida albicans 6,0–6,8.
Однако следует отметить, что полученные эффекты были продемонстрированы в отношении «диких» штаммов Acinetobacter baumannii, Klebsiella pneumoniae, Escherichia coli. В будущем мы предполагаем провести ряд экспериментов на полирезистентных госпитальных и внебольничных штаммах грамотрицательных патогенов Acinetobacter baumannii, Klebsiella pneumoniae, Escherichia coli.
ВЫВОДЫ
- Наилучшим образцом по показателю вязкости является гидрогель на основе 1% карбопола 940 с концентрацией меда 25%. Наименьшее значение вязкости наблюдается у 3,5% хитозана с низкой вязкостью.
- Наименьшей растекаемостью обладают образцы на основе 1% карбопола ETD2020 с концентрацией меда 50%. Наибольшая растекаемость отмечена у 3,5% хитозана с низкой вязкостью, что делает его нежелательным кандидатом для основы трансдермального покрытия.
- В целях достижения оптимального по вязкостным характеристикам и растекаемости покрытия рекомендовано в дальнейшем рассмотреть для исследования смешанный гидрогель из карбопола 940 и низковязкого хитозана.
- Наилучшая сорбционная емкость через 1 ч после начала испытания и через 3 ч продемонстрирована у образца на основе 3,5% низковязкого хитозана с концентрацией меда 25%.
- Наилучший результат высвобождения меда продемонстрировал образец на основе 10% низковязкого хитозана с концентрацией меда 50%. Образец на основе 3,5% низковязкого и высоковязкого хитозана оказался непригодным для исследования.
- Наиболее перспективными для дальнейшего изучения образцами по результатам исследования антибактериальных свойств признаны гидрогели на основе хитозана.
- На основании исследования физико-химических показателей данных гидрогелей, а также их антибактериальных свойств может быть рекомендовано провести испытания смешанного гидрогеля на основе карбопола 940 и 3,5% низковязкого хитозана.
- В результате сравнительного анализа было выявлено, что образцы гидрогелей с концентрацией меда 75% не проходят испытание на стабильность, что делает невозможным их применение в качестве терапевтической системы доставки.
Вклад авторов. Все авторы подтверждают соответствие своего авторства критериям ICMJE. Наибольший вклад распределен следующим образом: Е.Н. Карпина — наработка образцов, исследование их физико-химических свойств, интерпретация полученных результатов; Е.В. Федотова — контроль в процессе планирования и проведения исследования, сбор и анализ данных для работы, написание черновика рукописи, создание и подготовка рукописи; Ф.Ф. Зарипова — исследование антибактериальных свойств образцов in vitro, критический анализ черновика рукописи, внесение замечаний и исправлений; Д.В риворотов — сбор и анализ данных для работы, критический анализ работы на предмет научной новизны; А.С. Радилов — постановка задачи исследования, предоставление доступа к необходимым для исследования материалам, реагентам, веществам, лабораторным образцам, дизайн исследования, окончательное утверждение версии для публикации.
1. Общая фармакопейная статья «Буферные растворы». ОФС.1.3.0003. Государственная фармакопея Российской Федерации. XV издание. Доступ из справочно-правовой системы «КонсультантПлюс» (дата обращения: 21.07.2025).
2. CLSI. Performance Standards for Antimicrobial Susceptibility Testing. 33rd ed., CLSI supplement M100. Clinical and Laboratory Standards Institute; 2023.
3. EUCAST Disk Diffusion Method for Antimicrobial Susceptibility Testing Version 12.0 (January 2024). www.eucast.org
4. Методические указания. МУК 4.2.1890-04 «Методы контроля. Биологические и микробиологические факторы. Определение чувствительности микроорганизмов к антибактериальным препаратам» (утв. Главным государственным санитарным врачом РФ 04.03.2004). Доступ из системы «Консультант плюс» (дата обращения: 25.05.2025).
Список литературы
1. Bibire T, Panainte AD, Yilmaz CN, Timofte DV, Danila R, Bibire N, et al. Dexketoprofen-Loaded Alginate-Grafted Poly(N-vinylcaprolactam)-Based Hydrogel for Wound Healing. International Journal of Molecular Sciences. 2025;26(7):3051. https://doi.org/10.3390/ijms26073051
2. Surowiecka A, Struzyna J, Winiarska A, Korzeniowski T. Hydrogels in Burn Wound Management–A Review. Gels. 2022;8:122. https://doi.org/10.3390/gels8020122
3. Yao Y, Zhang A, Yuan C, Chen X, Liu Y. Recent trends on burn wound care: Hydrogel dressings and scaffolds. Biomaterials Science. 2021;9(13):4523–40. https://doi.org/10.1039/d1bm00411e
4. Chornopyshchuk R, Nagaichuk V, Gerashchenko I, Nazarchuk H, Kukolevska O, Choropyshchuk N, et al. Antimicrobial properties of a new polymeric material based on poly (2-hydroxyethyl methacrylate). Acta Bio-Medica: Atenei Parmensis. 2022;93(1):e2022012.
5. Romero-Antolin JA, Gomez-Cerezo N, Manzano M, Pablos JL, Valet-Regi M. Anti-inflammatory and Antibacterial Hydrogel Based on a Polymerizable Ionic Liquid. Acta Biomaterialia. 2025;196:78–92. https://doi.org/10.1016/j.actbio.2025.03.015
6. Maikovych O, Nosova N, Bukartyk N, Fihurka N, Ostapiv D, Samaryk V, et al. Gelatin-based hydrogel with antiseptic properties: synthesis and properties. Applied Nanoscience. 2023;13(12):7611–23. https://doi.org/10.1007/s13204-023-02956-6
7. Amanzholkyzy A, Zhumagaliyeva S, Sultanova N, Abilov Z, Ongalbek D, Donbayeva E, et al. Hydrogel Delivery System for Biological Active Substances: Properties and the Role of HPMC as a Carrier. Molecules. 2025;30(6):1354. https://doi.org/10.3390/molecules30061354
8. Li M, Qu H, Li Q, Lu S, Wu Y, Tang Z, et al. A carboxymethyl cellulose/chitosan-based hydrogel harvests robust adhesive, on-demand detachment and self-healing performances for deep burn healing. Chemical Engineering Journal. 2024;498:155552. https://doi.org/10.1016/j.cej.2024.155552
9. Nweze JA, Olovo CE, Nweze EI, Okechukwu OJ, Chidebelu P. Therapeutic Properties of Honey. In: de Toledo VA, Chambo ED, editors. Honey Analysis: New Advances and Challenges. London: IntechOpen; 2020:17–39. https://doi.org/10.5772/intechopen.86416
10. Albaridi NA. Antibacterial Potency of Honey. International Journal of Microbiology. 2019:1–10. https://doi.org/10.1155/2019/2464507
11. Sayadi SA, Zohdi RM, Shamshuddin NSS, Khairy MS, Hasan NA, Yasin AS, et al. Antifungal activity of selected Malaysian honeys: a comparison with Manuka honey. Journal of Coastal Life Medicine. 2015;3(7):539–42.
12. Francois AE, Gbaguidi B, Paraiso AA, Dah-Nouvlessounon D, Goubalan E, Baba-Moussa F, et al. Polyphenolic profile, and antioxidant and antifungal activities of honey products in Benin. African Journal of Microbiology Research. 2018;12(1):9–18. https://doi.org/10.5897/AJMR2017.8749
13. Khan RU, Naz S, Abudabos AM. Towards a better understanding of the therapeutic applications and corresponding mechanisms of action of honey. Environmental Science and Pollution Research. 2017;24(36):27755–66. https://doi.org/10.1007/s11356-017-0567-0
14. Talebi M, Talebi M, Farkhondeh T, Samarghandian S. Molecular mechanism-based therapeutic properties of honey. Biomedicine & Pharmacotherapy. 2020;130:110590. https://doi.org/10.1016/j.biopha.2020.110590
15. Tashkandi H. Honey in wound healing: An updated review. Open Life Sciences. 2021;16(1):1091–100. https://doi.org/10.1515/biol-2021-0084
16. Bahari N, Hashim N, Akim AM, Maringgal B. Recent Advances in Honey-Based Nanoparticles for Wound Dressing: A Review. Nanomaterials. 2022;12(15):2560. https://doi.org/10.3390/nano12152560
17. Molan P.C. Potential of Honey in the Treatment of Wounds and Burns. American Journal of Clinical Dermatology. 2001;2(1):13–9. https://doi.org/10.2165/00128071-200102010-00003
18. El-Kased RF, Amer RI, Attia D, Elmazar MM. Honey-Based Hydrogel: In Vitro and In Vivo Evaluation for Burn Wound Healing. Scientific Reports. 2017;7:9692. https://doi.org/10.1038/s41598-017-08771-8
Об авторах
Е. Н. КарпинаРоссия
Карпина Екатерина Николаевна
Санкт-Петербург
Е. В. Федотова
Россия
Федотова Елена Викторовна, канд. хим. наук
Санкт-Петербург
Ленинградская область
Ф. Ф. Зарипова
Россия
Зарипова Фалия Фуатовна, канд. биол. наук
Санкт-Петербург
Д. В. Криворотов
Россия
Криворотов Денис Викторович, канд. хим. наук
Ленинградская область
А. С. Радилов
Россия
Радилов Андрей Станиславович, д-р мед. наук, профессор
Ленинградская область
Рецензия
Для цитирования:
Карпина Е.Н., Федотова Е.В., Зарипова Ф.Ф., Криворотов Д.В., Радилов А.С. Медовый гидрогель — перспективное антибактериальное покрытие нового поколения? Экстремальная биомедицина. 2026;28(1):146-156. https://doi.org/10.47183/mes.2025-347
For citation:
Karpina E.N., Fedotova E.V., Zaripova F.F., Krivorotov D.V., Radilov A.S. Honey-based hydrogel: A promising new-generation antimicrobial coating? Extreme Medicine. 2026;28(1):146-156. https://doi.org/10.47183/mes.2025-347
JATS XML








